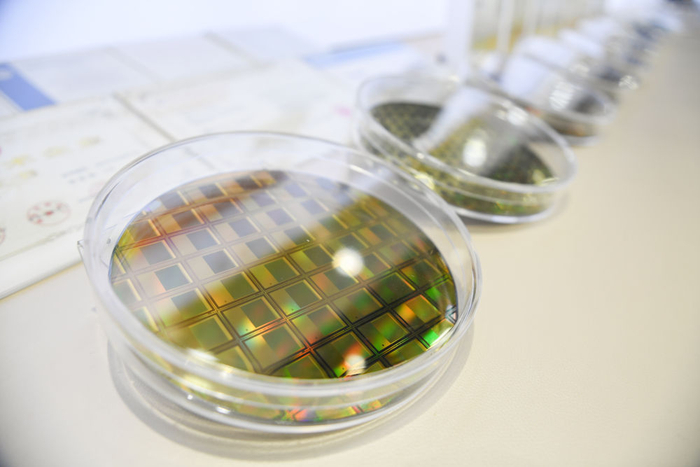
这是2月28日在武汉高德红外股份有限公司产品展厅内拍摄的展品。新华社记者 杜子璇 摄

这是2月28日拍摄的武汉高德红外股份有限公司(无人机照片)。新华社记者 杜子璇 摄
能见度不到100米的浓雾天气里,一架无人机腾空而起。通过机上红外探测系统,公安交管部门能清晰“看到”高架桥上缓行的车流,并有针对性地作出决策。
在物理学中,凡是高于绝对零度的物质,都会依据温度的不同对外辐射电磁波。利用这一特性,红外探测技术成为突破人类视觉障碍探测物体的利器。高灵敏度、高可靠性、高分辨率的红外探测核心器件更是各国角逐的焦点。
20多年来,武汉高德红外股份有限公司(以下简称“高德红外”)从零起步、不等不靠、勇往直前,成功研制出拥有完全自主知识产权的红外探测器芯片,有效打破国外垄断,解决国内重大需求。
十年磨一“芯”
位于武汉的中国光谷,新春开工正忙。高德红外终端生产线上,身穿静电服的工作人员正在调试一款观瞄型热成像夜视仪。透过生产线测试屏幕,只见影像正随温度变化,呈现出不同亮度和色块。

2月28日,在高德红外智感科技民品生产线上,工作人员对红外热成像仪进行程序烧录。新华社记者 杜子璇 摄
“你看,脸部整体高亮,但戴眼镜的地方就偏黑,这是因为散发的能量温度不同。”高德红外董事长黄立介绍,红外探测器芯片可以把肉眼不可见的红外线,转化为光电信号和成像,帮助人们更好洞悉身边环境。“这款夜视仪很受户外爱好者青睐,很快将出口海外。”

黄立(右三)与科研人员在高德红外生产调试车间忙碌(2020年2月11日摄)。新华社发
作为红外行业领军企业,高德红外年产各类红外产品150多万台,销往全球70多个国家和地区。在民用热成像市场的占有率居中国第一、全球第二。这些放在十多年前,简直是难以想象。
高德红外成立之初主要用进口芯片组装工业用红外测温仪。由于国外出口管制,长期以来,中国企业只能进口最低端的芯片,且数量少、价格高、交货周期长。“卖给你的芯片连售后都没有,你爱要不要。”黄立说,即便这样,2008年高德红外还是遭遇进口芯片断供。
“芯片就是‘心脏’,没有它,企业的命运就掌握在别人手里,随时可能死亡。”黄立逐渐意识到,关键核心技术是要不来、买不来、讨不来的。于是,高德红外开启了漫漫“追芯”路。
“从零起步,任何一个技术难点都会让你‘卡壳’。”2009年入职高德红外的中国科学院上海技术物理研究所博士周文洪说,氧化钒是制造红外芯片的基本原料,它的配比及加工时的温度、气压等直接关系芯片性能。没有技术参考,科研人员只能“硬刚”,“耗时2年多、1000多次试验,相关问题才得以攻克。”
缺技术,就翻遍资料文献寻找蛛丝马迹;缺设备,就借用外地专业院所机器开展样品研发;缺材料,就托人东挪西借,有一点用一点;缺资金,就提高研发经费投入强度,将上市募资全部用于研发……
历经9年多时间、投资近20亿元、突破数百项技术难题和数千项工艺难关,高德红外自主研发的高性能制冷单色百万像素红外探测器芯片于2017年成功面世,2018年实现量产。这一国产红外芯片的问世,直接将同类型进口产品价格拉低50%以上。
攀登无止境
走进高德红外产品展厅,几十款大大小小、形状各异的红外探测器映入眼帘。它们有的只有指甲盖大小,却集成了传感器等重要设备;有的被厚重金属外壳包裹,可适应零下200摄氏度的极端工作环境;有的可装载在其他设备上,能够高灵敏度、全天候、全被动工作……
这是2月28日在武汉高德红外股份有限公司产品展厅内拍摄的展品。新华社记者 杜子璇 摄
一款款红外探测器,展示了高德红外的技术实力,更彰显着企业坚定自主创新、把科技命脉牢牢掌握在自己手中的决心。

这是2月28日在武汉高德红外股份有限公司产品展厅内拍摄的展品。新华社记者 杜子璇 摄
黄立介绍,高德红外在生产出单色百万像素红外探测器芯片时,少数国家已掌握双色百万像素红外探测器芯片技术,我国在此方面与之差距明显。
红外芯片要实现从“单色”到“双色”突破,并非易事。高德红外芯片研发负责人刘斌介绍,红外芯片要通过读出电路,将光转化成电子后,采集放大并以视频格式输出。这需要电路与芯片互联互通。一个双色芯片有130多万个像素,每个像素都有一个焊点,要在蚕豆大小的芯片上制备如此密集的焊点并确保互联互通异常困难。
刘斌说,焊接双色红外芯片的倒装焊接机精度要求在1微米以下,而当时国内只有3微米左右倒装焊接机,且无法进口高精度设备。高德红外研发人员只好不停地试验、总结、修改方案。最终,一举攻克了让130多万个像素点连通率达99.99%以上的微组装技术难题。
从单色百万像素芯片到双色百万像素芯片,高德红外瞄准国际领先技术的脚步从未停歇。目前,该企业已搭建起非制冷探测器、制冷型碲镉汞及二类超晶格3条完全自主可控的批量生产线,具备多种型号探测器芯片的研制生产能力。公司核心器件技术水平已与西方国家第一梯队持平,并成功实现核心器件全面国产化。
融合再跨越
2月22日15时02分,武汉东湖新技术开发区,一架无人机在空中巡查发现,雄楚大道高架往关山大道方向的匝道有车辆因道路结冰陷车,导致拥堵。公安交管部门随即派出警力铲冰除雪,15时20分,道路恢复畅通。
“这架无人机之所以如此精准,因为它有双‘高清红外眼睛’。”武汉市公安局东湖新技术开发区分局相关负责人介绍,借助实时回传的高清红外画面,指挥中心能够全天候掌握道路结冰、交通拥堵等路况信息,进行科学决策。
正是因为中国自主红外芯片的突破,红外热成像技术才大范围普及。目前高德红外部分型号的红外芯片成本已降到几百元,随着红外核心芯片小型化、低成本、高可靠性、大批量生产的实现,红外科技产品迎来飞入寻常百姓家的契机,也为千行百业的迭代更新带来更大的想象空间。
自动驾驶集成红外模块,可穿透黑暗、雨雾精准发现行人,保证驾驶安全;智能空调集成红外模块,可根据人员数量、方位、姿态调节风向风速,既节能又精准;电力线路检测整合红外模块,可更快发现温度异常和隐患,提高检测精度和效率……高德红外的探测器已被广泛应用于人体测温、工业测温、安防监控、消防救援、户外运动、自动驾驶等领域。

2月28日,在高德红外智感科技民品生产线上,工作人员在操作设备对红外模组进行数据采集。新华社记者 杜子璇 摄
当前,高德红外正全面打造红外“芯”平台战略,围绕产业链部署创新链,围绕创新链布局产业链。通过不同行业、企业间优势互补、资源共享,推动红外技术的规模化、多样化、普及化和消费化,共同打造红外生态圈。
“有人跟我说,红外芯片研发是国家的事,民企没必要折腾,但事实证明,掌握核心技术,实现自立自强,每个人都义不容辞。”黄立说,正是由于坚持不懈地推进自主创新,高德红外才取得了今天的成绩。
“没有做不到的,只有想不到的。”在高德红外园区中心花园里,镌刻着这样一句话,往来员工会不由自主地抬头看看。“每一代人都有自己的机遇,我们不能辜负这个伟大的时代。”不少员工如是说。

文字记者:李鹏翔、徐海波、王自宸
视频记者:余国庆、饶饶、潘志伟
编辑:储兴华、王化娟、郑雅宁、张浩波、徐金泉、侯帮兴、郭洁宇
统筹:黄小希、何雨欣


